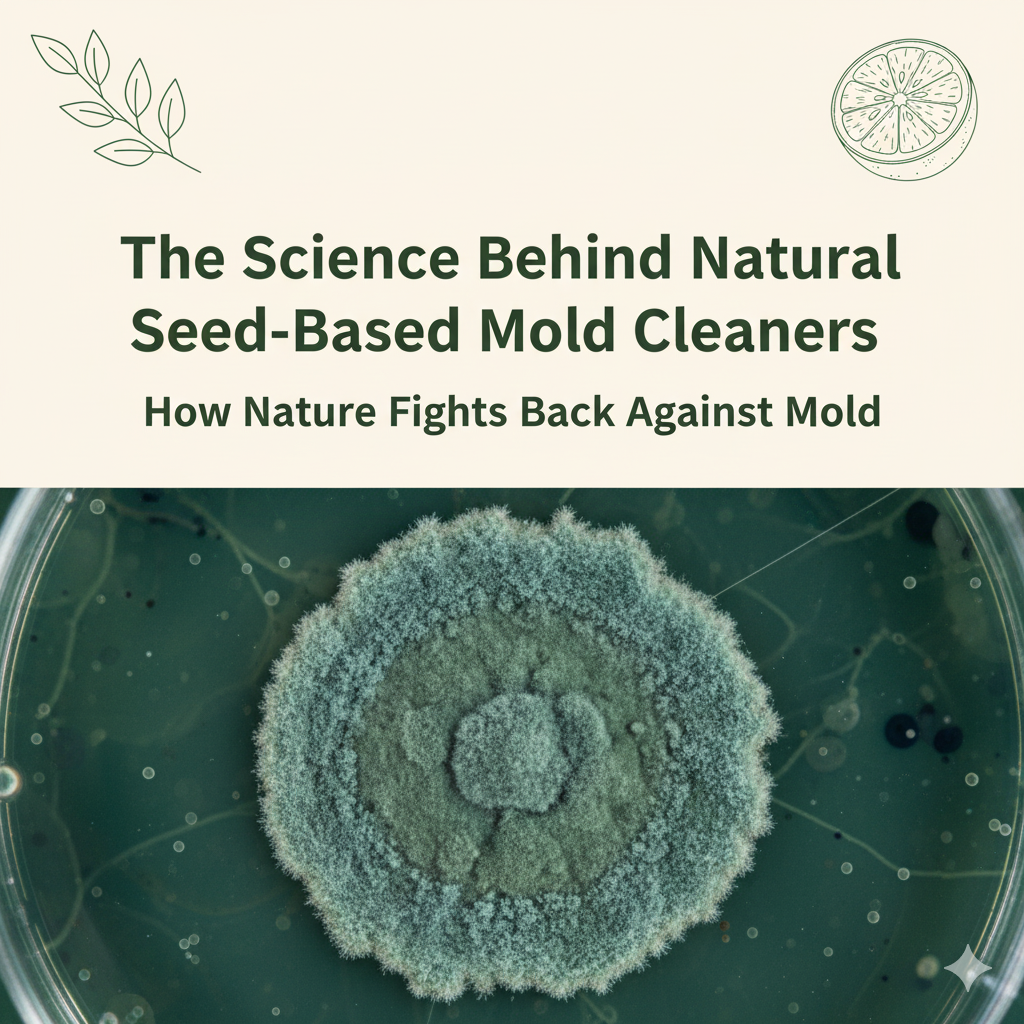
The rise of natural seed-based mold cleaners

The rise of natural seed-based mold cleaners
Share
The Science Behind Natural Seed-Based Mold Cleaners: How Nature Fights Back Against Mold
When most people think about tackling mold, they picture harsh chemicals, bleach fumes, and gloves thick enough for a lab experiment. But what if nature already offered a safer, equally effective way to manage mold — one that doesn’t fill your home with toxic residues or chemical smells? Enter the natural seed-based mold cleaner, a plant-powered innovation rooted in both ancient wisdom and modern science.
In this article, we’ll explore how these natural cleaners work, why they’re gaining popularity, and what the science really says — including some of the common myths and limitations surrounding their effectiveness.
🌿 Why Mold Control Needs a Rethink
Mold isn’t just an aesthetic nuisance — it’s a living organism that spreads microscopic spores through the air. These spores can cause respiratory irritation, allergies, and material decay, particularly in damp environments.
Traditional cleaning solutions often rely on chlorine bleach, ammonia, or industrial biocides. While powerful, they come with downsides:
- High levels of volatile organic compounds (VOCs) that reduce indoor air quality
- Corrosive effects on surfaces and fabrics
- Environmental persistence, harming waterways and soil microbes
- Health risks from long-term exposure
As consumers grow more eco-conscious, demand for non-toxic, biodegradable alternatives has fueled the rise of biobased mold cleaners — many of which use natural seed extracts to inhibit mold growth safely.
🌰 Seeds: Nature’s Built-In Antifungal Defense
Seeds are small but mighty. Their purpose is to protect new life, so they’ve evolved complex biochemical defenses to resist mold, bacteria, and decay. These defenses come from bioactive compounds — natural chemicals that stop microbial invaders in their tracks.
Here are a few examples of antifungal seed components:
- Citrus seeds – Contain flavonoids and limonoids that attack fungal cell membranes.
- Grapefruit and grape seeds – Rich in polyphenols that interrupt fungal growth cycles.
- Pumpkin seeds – Contain proteins and fatty acids with mild antimicrobial activity.
- Neem and moringa seeds – Used traditionally for their broad antifungal and antiseptic properties.
By isolating and concentrating these compounds, modern eco-cleaning companies create natural seed-based mold cleaners that neutralize spores while staying gentle on the environment.
🔬 The Science: How Natural Seed-Based Mold Cleaners Work
Unlike chemical disinfectants that “burn away” mold, seed-based cleaners rely on biochemical interference. Here’s what that means in simple terms:
- Cell Wall Breakdown – Plant-derived compounds like bioflavonoids and phenolics damage the outer membrane of mold spores, making them unable to germinate.
- Enzyme Inhibition – Natural acids interfere with the enzymes fungi use to metabolize nutrients, effectively starving the spores.
- Oxidative Stress – Some seed extracts generate mild oxidative effects that disable fungal DNA and slow reproduction.
- Residual Suppression – A thin film of bioactive residue remains on the surface, continuing to suppress spore activity for hours or even days.
This multi-pronged approach not only removes existing spores but also discourages regrowth — all without synthetic chemicals.
🌎 Eco-Friendly and Health-Safe Advantages
- Non-toxic & biodegradable: Breaks down naturally, posing no threat to waterways or ecosystems.
- Safe for sensitive households: Ideal for homes with pets, children, or people with allergies.
- Low-VOC formulation: Improves indoor air quality instead of degrading it.
- Sustainably sourced: Many formulas use by-products from seed and fruit industries, reducing agricultural waste.
- Gentle but effective: Works on a wide range of surfaces without etching or discoloration.
For homeowners who care about both health and sustainability, natural seed-based mold cleaners provide an appealing alternative to harsh chemical options.
🧴 Where These Cleaners Work Best
- Bathrooms: Grout lines, shower tiles, and damp corners.
- Kitchens: Under-sink areas, refrigerator seals, and dishwashers.
- HVAC systems: Sprayed onto filters to minimize spore circulation.
- Fabrics & upholstery: Ideal for soft materials that can’t tolerate bleach.
- Basements & attics: Areas prone to moisture and stale odors.
Routine use can keep spore counts low, reduce musty smells, and maintain a cleaner environment.
⚖️ Comparing to Chemical Mold Cleaners
| Feature | Chemical Mold Cleaners | Natural Seed-Based Mold Cleaners |
|---|---|---|
| Active Mechanism | Harsh oxidation and corrosion | Enzyme disruption and cell wall breakdown |
| Health Impact | Can irritate eyes, skin, lungs | Hypoallergenic and safe for daily use |
| Environmental Footprint | High VOCs, synthetic runoff | 100% biodegradable |
| Surface Safety | May damage porous materials | Safe for wood, fabric, paint |
| Residual Protection | Limited | Natural antifungal barrier |
⚠️ The Drawbacks and Myths About Natural Mold Cleaners
🧠 Myth 1: “Natural means weaker.”
Not necessarily. Lab studies show that citrus and grape seed extracts can inhibit mold as effectively as chemical biocides — but they often require a longer contact time to achieve full effect.
⚡ Myth 2: “They kill all mold instantly.”
Seed-based formulas disrupt spore activity rather than obliterate colonies on contact. They excel in maintenance cleaning and spore reduction, not deep structural remediation.
💸 Drawback 1: Cost per ounce can be higher
Because they use sustainable, high-quality ingredients, natural cleaners can be pricier than bleach. However, they’re concentrated and multi-purpose, balancing long-term value.
🧴 Drawback 2: Requires consistency
Natural cleaners work best as part of routine cleaning. Skipping regular use may allow mold spores to return over time.
🧩 Myth 3: “All seed-based cleaners are the same.”
Different seeds produce unique antifungal compounds. Always check for independent lab testing to ensure real efficacy.
💧 Prevention: The Missing Piece of the Puzzle
Even the best cleaner can’t fix a moisture problem. Mold thrives in humidity, so the foundation of any mold-control plan is dryness and airflow:
- Keep humidity below 60% with dehumidifiers.
- Repair leaks immediately.
- Vent bathrooms and kitchens.
- Clean and dry damp areas within 24 hours.
- Use a natural seed-based mold cleaner regularly for maintenance.
Think of mold control as 70% moisture management, 30% cleaning science.
🌱 The Future of Green Cleaning
The rise of natural seed-based mold cleaners reflects a broader shift toward green chemistry — harnessing plant biochemistry to protect both people and the planet. Instead of fighting nature with harsh synthetics, we’re learning to use its own defense systems. Seeds evolved to preserve life; now, we’re borrowing that wisdom for our homes.
✨ Final Thoughts
Nature doesn’t just grow mold — it also grows the answer. By choosing a natural seed-based mold cleaner, you’re not only removing spores; you’re embracing a smarter, sustainable approach to cleanliness.
Science and sustainability don’t have to be at odds — sometimes, the most advanced solutions start in the simplest place: a seed. 🌰
